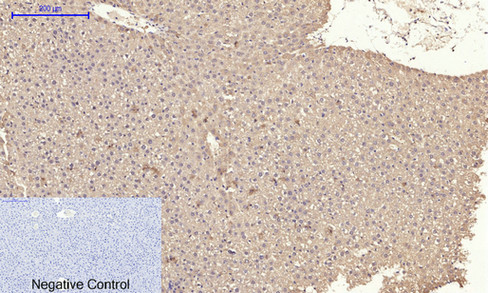
14 - IRS-1 Polyclonal Antibody AP70587

IRS-1 Polyclonal Antibody
- 产品详情
- 实验流程
- 背景知识
Application
| WB, IHC-P, IF, ICC, E |
|---|---|
| Primary Accession | P35568 |
| Reactivity | Human, Mouse, Rat, Pig |
| Host | Rabbit |
| Clonality | Polyclonal |
| Calculated MW | 131591 Da |
| Gene ID | 3667 |
|---|---|
| Other Names | IRS1; Insulin receptor substrate 1; IRS-1 |
| Dilution | WB~~Western Blot: 1/500 - 1/2000. Immunohistochemistry: 1/100 - 1/300. Immunofluorescence: 1/200 - 1/1000. ELISA: 1/20000. Not yet tested in other applications. IHC-P~~Western Blot: 1/500 - 1/2000. Immunohistochemistry: 1/100 - 1/300. Immunofluorescence: 1/200 - 1/1000. ELISA: 1/20000. Not yet tested in other applications. IF~~1:50~200 ICC~~N/A E~~N/A |
| Format | Liquid in PBS containing 50% glycerol, 0.5% BSA and 0.09% (W/V) sodium azide. |
| Storage Conditions | -20℃ |
| Name | IRS1 |
|---|---|
| Function | Signaling adapter protein that participates in the signal transduction from two prominent receptor tyrosine kinases, insulin receptor/INSR and insulin-like growth factor I receptor/IGF1R (PubMed:7541045, PubMed:33991522, PubMed:38625937). Plays therefore an important role in development, growth, glucose homeostasis as well as lipid metabolism (PubMed:19639489). Upon phosphorylation by the insulin receptor, functions as a signaling scaffold that propagates insulin action through binding to SH2 domain-containing proteins including the p85 regulatory subunit of PI3K, NCK1, NCK2, GRB2 or SHP2 (PubMed:11171109, PubMed:8265614). Recruitment of GRB2 leads to the activation of the guanine nucleotide exchange factor SOS1 which in turn triggers the Ras/Raf/MEK/MAPK signaling cascade (By similarity). Activation of the PI3K/AKT pathway is responsible for most of insulin metabolic effects in the cell, and the Ras/Raf/MEK/MAPK is involved in the regulation of gene expression and in cooperation with the PI3K pathway regulates cell growth and differentiation. Acts a positive regulator of the Wnt/beta-catenin signaling pathway through suppression of DVL2 autophagy-mediated degradation leading to cell proliferation (PubMed:24616100). |
| Cellular Location | Cytoplasm. Nucleus. Note=Nuclear or cytoplasmic localization of IRS1 correlates with the transition from proliferation to chondrogenic differentiation. |
Research Areas
For Research Use Only. Not For Use In Diagnostic Procedures.
Application Protocols
Provided below are standard protocols that you may find useful for product applications.
BACKGROUND
May mediate the control of various cellular processes by insulin. When phosphorylated by the insulin receptor binds specifically to various cellular proteins containing SH2 domains such as phosphatidylinositol 3-kinase p85 subunit or GRB2. Activates phosphatidylinositol 3-kinase when bound to the regulatory p85 subunit (By similarity).
终于等到您。ABCEPTA(百远生物)抗体产品。
点击下方“我要评价 ”按钮提交您的反馈信息,您的反馈和评价是我们最宝贵的财富之一,
我们将在1-3个工作日内处理您的反馈信息。
如有疑问,联系:0512-88856768 tech-china@abcepta.com.
¥ 1,500.00
Cat# AP70587























 癌症的基本特征包括细胞增殖、血管生成、迁移、凋亡逃避机制和细胞永生等。找到癌症发生过程中这些通路的关键标记物和对应的抗体用于检测至关重要。
癌症的基本特征包括细胞增殖、血管生成、迁移、凋亡逃避机制和细胞永生等。找到癌症发生过程中这些通路的关键标记物和对应的抗体用于检测至关重要。 为您推荐一个泛素化位点预测神器——泛素化分析工具,可以为您的蛋白的泛素化位点作出预测和评分。
为您推荐一个泛素化位点预测神器——泛素化分析工具,可以为您的蛋白的泛素化位点作出预测和评分。 细胞自噬受体图形绘图工具为你的蛋白的细胞受体结合位点作出预测和评分,识别结合到自噬通路中的蛋白是非常重要的,便于让我们理解自噬在正常生理、病理过程中的作用,如发育、细胞分化、神经退化性疾病、压力条件下、感染和癌症。
细胞自噬受体图形绘图工具为你的蛋白的细胞受体结合位点作出预测和评分,识别结合到自噬通路中的蛋白是非常重要的,便于让我们理解自噬在正常生理、病理过程中的作用,如发育、细胞分化、神经退化性疾病、压力条件下、感染和癌症。

.jpg)





